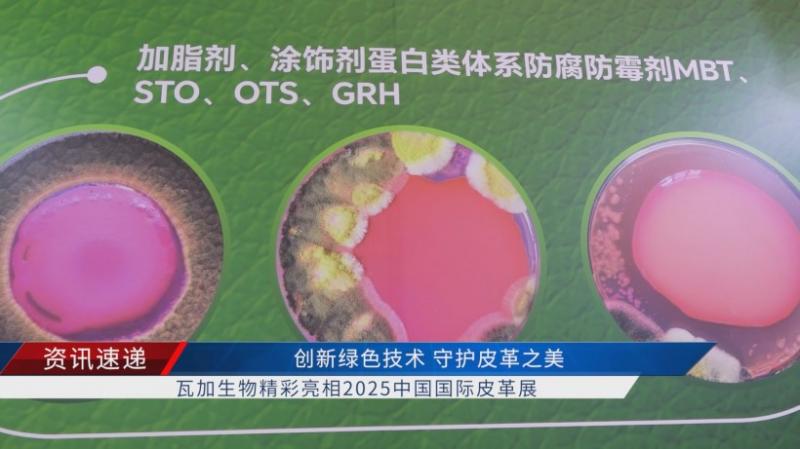

2025中国国际皮革展在上海启幕,上海瓦加生物科技有限公司携全新抗菌、防霉解决方案惊艳亮相,为汽车内饰、高端家居及箱包产业注入安全、环保新动能。

上海瓦加生物科技有限公司总经理梅印伟在接受一财记者采访时,详细介绍了此次参展的两大特色亮点。他表示:“本次展会我们有两大特色:第一个,我们在这个新型的汽车抗菌方向盘、抗菌面板,我们采用了全新的抗菌剂680,它(相)较传统的这个抗菌剂,对人体的皮肤刺激性更小,而且对霉菌的抑制范围也更宽。第二,我们在针对一些高档的这个家居、箱包,推出了一些新款的防霉剂,它采用了纯天然抗菌植物提取液加传统抗菌技术的融合,让皮革充满了时尚的魅力。”

现阶段,随着新能源汽车渗透率持续攀升,座舱健康已成为整车厂差异化竞逐的核心赛道。瓦加生物依托德国技术平台与多年微生物控制经验,集中攻克天然植物抗菌剂的稳定性、长效性难题,携手各大车企在全球供应链中率先占领环保高地。
谈及未来发展规划,梅印伟信心满满地表示:“我们目前和一些新的能源汽车在合作,做一些抗菌面板、抗菌方向盘和一些新型的汽车抗菌座椅,我们已经和全国各大汽车合作厂商建立了普遍的联系和良好的合作关系。未来我们将进一步在新能源汽车抗菌防霉(领域)继续加大天然植物的这个抗菌(剂)的研发,让汽车内饰不再是细菌和霉菌的温床,让驾驶充满了愉悦与安全。”

从传统皮革到智能座舱,从化学杀菌到植物守护,上海瓦加生物科技有限公司正以微生物控制技术为笔,描绘安全、低碳、可持续的产业新图景。
记者陈美琴、侍勤勤报道。
本节目于上海东方财经频道播出,本文内容为初稿样片整理版,供参考。以最终电视台播出版本为准。
责编:陈美琴 高飞 陈茜 郭莹 邢善良 聂平 孔祺琪
编导:侍勤勤
后期:田旭

 广通社
广通社










